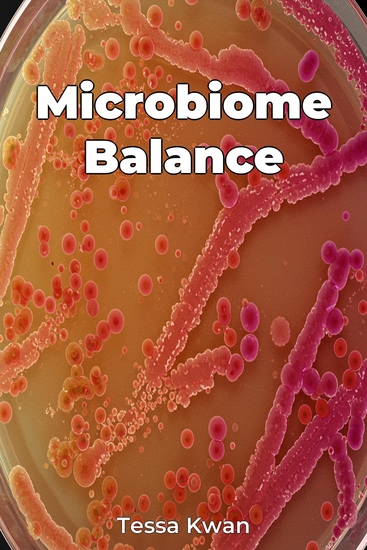

Microbiome Balance
Tessa Kwan
Tradutor A AI
Editora: Publifye
Sinopse
Microbiome Balance explores the fascinating connection between your gut and overall health, revealing how gut bacteria profoundly impact digestion, mental health, and immunity. It highlights that the trillions of microorganisms residing within us aren't just freeloaders; they play a vital role in digesting food, synthesizing essential vitamins, and even regulating mood via the gut-brain axis. The book emphasizes that modern lifestyles and widespread antibiotic use can disrupt this delicate ecosystem, leading to various health problems, including digestive disorders like irritable bowel syndrome (IBS) and inflammatory bowel disease (IBD). The book uniquely addresses the root causes of many health issues by focusing on achieving and maintaining a balanced gut microbiome through proactive strategies. Initially, it introduces core concepts such as gut bacteria diversity and influencing factors. Subsequent chapters delve into how an imbalanced microbiome contributes to digestive and mental health disorders. It then progresses to explore the microbiome's impact on the immune system, including its role in preventing autoimmune diseases and allergies. This approach provides a complete understanding of gut health and its extensive implications, offering readers evidence-based strategies to improve their overall quality of life.














